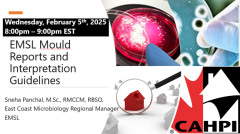
Image Not Found

WELCOME!
The eLearning portal provides home inspectors across Canada with the opportunity to learn from industry experts. There are various topics, from business to technical to industry issues of interest along with Affiliate product & service demos!
We invite all inspectors to enroll in these courses for a nominal fee to earn annual continuing education credits.